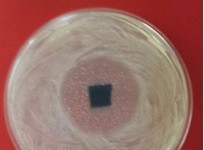
Серебряная эсенция

Система компьютерного моделирования Illustris завершила создание виртуальной Вселенной (видео)
Для опытного физика, который занимается вычислениями с помощью компьютера, нет ничего секретного в том, что создание масштабных физических процессов с помощью компьютер...
Цвет макияжа можно выбрать самостоятельно, используя принтер Mink 3D (видео)
Одной из самых распространенных проблем при выборе макияжа является выбор ее оттенка. Чаще всего женщина нуждается в особом оттенке цвета, которого может не быть на при...
iTie – с этим галстуком Вы покорите всех
Если кто-то считает себя недостаточно помешанным на компьютерных технологиях личностью, то можете включить в свой гардероб галстук от Apple - iTie. Этот уникальный в св...
Электронный аэратор Vinaera Electronic – эффективность и удобство
Возможно, новый аэратор Vinaera Electronic станет альтернативой известному прибору для насыщения кислородом Vinturi. Эта разработка основывается на результатах 5-летних...
Самый маленький в мире комикс уместился на волосе человека (видео)
С давних времен, человек пытался запечатлеть свою историю. Вначале развития человека – это были наскальные рисунки, далее научились вырабатывать чернила, а современный ...
Итальянский велосипед Сада складывается до размеров зонтика (видео)
За достаточно короткий период времени, рынок современных велосипедов пополнился несколькими изобретениями. Такие модели складываются до небывало малых размеров и с ними...
Новая губка впитывает масло, отталкивая воду
Одной из самых больших проблем при использовании нефти, является ее уборка в случае аварии. Данные аварии чреваты экологическими катастрофами, который могут нанести сер...
Nano Lure позволяет поймать крупную рыбу (видео)
Рыболовы уверены, что бесценный опыт получается в результате создания наживок самостоятельно. Но, проблемой таких способов, чаще всего, является невозможность использов...
Новая антибактериальная ткань делает чудеса
Материал серебро отличается способностью уничтожать бактерии и вирусы, которые попадают в организм человека. Современные технологии позволяют использовать данный матери...
Игорь Чак представил новую модель мотоцикла Honda Super 90 (видео)
На церемонии, приуроченной 50-летию Honda Super 90, дизайнер родом из Владивостока, презентовал свой концепт этой модели. За основу были взяты черты классического дизай...